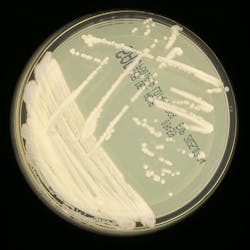
Candidozyma auris on standard Sabauraud dextrose agar. Candidozyma auris on standard Sabauraud dextrose agar.
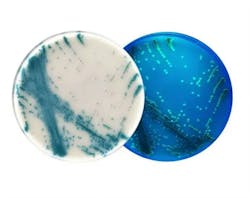
Candidozyma auris on chromogenic media. Candidozyma auris on chromogenic media.

Modernizing microbiology: Achieving balance between comprehensive insights and efficiency
Within the steady rhythm of today’s laboratory, microbiology stands at a pivotal moment. Once quietly supporting infection control, these labs now drive the global response to pathogens that adapt faster than traditional methods can keep pace. New threats like Candidozyma (formerly Candida) auris, a deadly drug-resistant yeast, and persistent pathogens like Clostridioides (formerly Clostridium) difficile demand faster, more accurate testing methods.
Accurate pathogen identification and susceptibility testing are essential for guiding patient treatment and preventing outbreaks. However, laboratories now face a critical paradox: as the range of pathogens grows, efficiency must increase despite shortages in staff and resources.
Emerging microbiology challenges
Candidozyma auris
First reported in 2009, Candida auris — now Candidozyma auris — quickly became a global health concern due to its resistance to multiple antifungal drug classes, environmental persistence, and association with high mortality in healthcare settings.1 Detected on all inhabited continents by 2018, the CDC and WHO now classify the infection as an urgent threat and critical priority for the protection of global health.2
The laboratory identification of C. auris can be challenging, but recently, scientists have developed a chromogenic medium to identify the yeast.3 This is a prime example of where traditional microbiology approaches can assist in the detection and guided intervention of infections in healthcare settings. By producing distinct colors for C. auris, the chromogenic medium has been shown to correctly identify the majority of C. auris isolates in early studies, with minimal false positives.4
Clostridioides difficile
Clostridioides difficile (C. difficile) continues to evolve as well, with hypervirulent strains causing severe, recurring infections that challenge even the most robust infection control efforts. Its capacity to form resilient spores and persist on surfaces complicates eradication — particularly in healthcare systems full of immunocompromised or susceptible patient populations.
Technological innovations in microbiology solutions
When it comes to these emerging threats, the field of microbiology has been quick to innovate, providing new solutions that empower clinical labs to better identify and take appropriate action in the face of growing infection risk. This innovation has been guided by two key themes: the need to reduce human error and improve consistency, and the ability to combine varied diagnostic platforms for a more holistic and accurate picture of infection.
Reducing human error and increasing consistency
Chromogenic culture media enable visual differentiation of pathogens like MRSA, VRE, CRE, and C. auris, reducing interpretation errors and streamlining workflows.4 In a more democratized approach that is helping advance microbiology performance, multiplex molecular panels can also integrate pathogen detection and resistance gene identification, shortening time-to-results and enabling targeted treatment.
The introduction and advancement of artificial intelligence–enabled data interpretation tools is also helping increase consistency in culture media analysis.5 AI has the potential to help fill the knowledge gaps in skilled labor that are increasing in the lab by helping interpret test results and helping lab technicians feel confident in their results. Unfortunately, these tools are still in early stages, so while there’s vast potential, most systems are currently used in larger, more well-resourced microbiology labs and haven’t yet advanced to more widespread availability.
Combining advanced diagnostic platforms
The integration of molecular platforms, such as multiplex PCR, loop-mediated isothermal amplification (LAMP), and even CRISPR-based assays, has also further advanced detection, enabling labs to identify multiple pathogens and resistance genes in a single run. Further, technological enhancements have helped reduce turnaround times from days to hours. PCR-based rapid detection, such as TaqMan assays for C. difficile ST1, provide accuracy, support infection control and enhance antimicrobial stewardship by reducing overtreatment. Each of these new tests has helped revolutionize microbiology—allowing us to improve efficiency and access to diagnostics to help treat and manage illnesses more effectively.
Operational challenges and strategic solutions
However, adopting new technologies requires careful planning. Amid the challenges posed by the infections themselves, microbiology and clinical labs must also navigate industrywide logistical challenges such as a need for vendor consolidation and shortages in staff and resources.
According to a recent survey by the American Society for Clinical Pathology, “Staff layoffs, reduced hours, or hiring freezes can strain the workforce, leading to increased workloads and potential burnout.”6 While these operational changes may initially pose hurdles, they also offer an opportunity to rethink how these labs work and integrate across the industry.
How can labs advance without compromising efficiency or quality?
Training lab staff and partnering with reliable vendors are essential to ensure these systems are used effectively. By balancing innovation with efficiency, microbiology labs can better detect and respond to the growing threat of new infections, protecting patients and public health alike.
For example, the notion of vendor consolidation can be ominous as lab leaders consider the internal resistance to change. However, consolidating around uniform platforms also offers immense benefits, such as reducing supply chain complexity, simplifying validation, and lowering training requirements. A detailed cost–benefits analysis can help assess when it is the right time for each lab to consider this type of move, evaluating initial platform cost and change management against the longer-term benefits.
And while grappling with staffing shortages can also be daunting, rethinking who does what in a lab setting — and where automation or technology could lend a helping hand — may in fact identify new efficiencies moving forward. To take advantage of these emerging technologies, staff training is paramount. Introducing complex molecular or analytical methods requires sustained competency development and relationships with vendors who provide effective support.
Conclusion
Progress in microbiology demands both curiosity and clarity. In confronting emerging pathogens like C. auris and C. difficile, as well as their evolution with antimicrobial resistance, clinical microbiology laboratories must evolve by integrating technological innovation with efficient operations. Tools like chromogenic media, AI-enabled interpretation platforms, molecular assays, and emerging diagnostics offer comprehensive insight without compromising throughput. Strategic planning, including vendor standardization and staff training, ensures these technologies enhance rather than burden clinical workflows. With this balanced approach, microbiology labs can strengthen both diagnostics and public health preparedness.
REFERENCES
1. Nutt K. Deadly climate change fungus targeted in drug project. The Times. Published July 6, 2024. Accessed July 25, 2025. https://www.thetimes.com/uk/scotland/article/deadly-climate-change-fungus-targeted-in-drug-project-l0kbnmmwp.
2. Lyman M, Fox A, Zhu Y, et al. Epidemiology and clinical outcomes of Candida auris infections in the United States, 2017–2022. Open Forum Infect Dis. 2024;11(6):ofad681. doi:10.1093/ofid/ofad681.
3. Morales-López S, Parra-Giraldo CM, Ceballos-Garzón A, Rodríguez GJ, Álvarez-Moreno C, Rodríguez JY. Utility of CHROMagar Candida Plus for presumptive identification of Candida auris from surveillance samples. Published online November 2022. Accessed July 25, 2025. https://www.researchgate.net/publication/365291857.
4. Kordalewska M, Pasko MT, Kwon DH, et al. Retrospective whole-genome sequencing analysis distinguishes independent outbreaks of Candida auris in New York. Microbiol Spectr. 2024;12(3):e03564-23. doi:10.1128/spectrum.03564-23.
5. Reese H, Wallace M, Vugia DJ, et al. Multistate outbreak of echinocandin-resistant Candida auris infections linked to a skilled nursing facility — California, 2021–2022. MMWR Morb Mortal Wkly Rep. 2024;73(13):273-279. doi:10.15585/mmwr.mm7313a2.
6. Kelly SL, Rautemaa-Richardson R, Richardson MD. Molecular mechanisms of antifungal resistance. Manchester Fungal Infection Group. Published 2022. Accessed July 25, 2025. https://static1.squarespace.com/static/603ab50ab81d5532a0a4a42b/t/62e7f142e363ce5e988573fc/1659367747105/1+Kelly+et+al.pdf.
About the Author

Steve Dimmer
is a Staff Scientist and Biological Safety Officer at Thermo Fisher Scientific. With over 30 years of experience in clinical microbiology and research, he combines scientific rigor with leadership to drive innovative product development and design excellence across the organization.